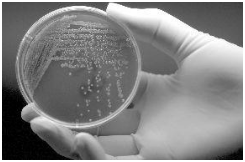

靶向药百科
*以上解读内容仅供参考,癌症123不对解读内容负责。
被感染了乙肝的患者吃多吉美有用吗
2018-03-28国内目前乙肝的感染者是非常之多的,而且我们都知道多吉美(索拉菲尼)是显著延长晚期HcC患者总生存率的系统性治疗药物,而且生存期可增加到44%,而且作为乙肝感染的大国,吃多
帕博西尼是乳腺癌患者的首选
2018-03-28目前,对于乳腺癌治疗是非常众多的额,而且乳腺癌的治疗药物也是非常之多,对于治疗药物稀缺的患者来看,在早期都可以通过手术治疗,而早期一般都非常难以发现,而一般都是晚期的
为何中国患者使用多吉美效果最棒!
2018-03-28多吉美被认为是治疗肝癌的一线用药,而且多吉美的疗效非常神奇,能显著延长肝癌患者的生存期10.7个月,而且这也突破了过去肝癌患者的治疗局限,以前都是采用手术或者放疗的手
肝癌一线疗法多吉美到底疗效如何?
2018-03-28多吉美已经被美国食品药品监督管理局认定为肝癌的一线疗法,而且疗效非常好,并且在中国上市的十几年间,确实为患者带来了非常大的安慰,延缓了患者的生存期10.7个月。
激素受体调节剂氟维司群作用大
2018-03-28乳腺癌一直威胁着我们的身体和心灵,而且癌细胞如果一经扩散,后果非常严重,因此雌激素在乳腺癌的生长中起到至关重要的作用,内分泌治疗则是通过降低体内雌激素水平或抑制雌
重磅福利来袭,氟维司群被纳入医保!
2018-03-28作为乳腺癌内分泌治疗的代表药物,氟维司群的诞生给了我们更多的想象,而且国内乳腺癌一直呈现上升的趋势,而且对于晚期的乳腺癌患者来讲,氟维司群确实为现代乳腺癌的治疗增
他莫昔芬有效调控乳腺癌细胞生长
2018-03-28作为最新的雌激素受体调节剂他莫昔芬给我我们一个全新治疗乳腺癌的方法,而且相比之前的治疗方法来看,他莫昔芬确实让我们感受到激素药物带来的疗效非常大,下面我们来看一
他莫昔芬——雌激素受体阳性乳腺癌救星
2018-03-28最新的乳腺癌和卵巢癌的新药他莫昔芬,而且在临床上疗效非常好,所以他莫昔芬给了患者非常大的希望,而他莫昔芬目前已经在国内上市了,给好多乳腺癌患者带去了希望,尤其是雌激
赫赛汀为乳腺癌患者带来黎明的曙光!
2018-03-28我们知道,赫赛汀是一款治疗HER2 过度表达的转移性乳腺癌,而且给了我们非常大的信心和希望,而且赫赛汀作为最新款乳腺癌靶向药已经成功赢得了患者的认同,号称是为乳腺癌患者
赫赛汀为何会被如此推崇?
2018-03-28赫赛汀作为乳腺癌的靶向神药,而且疗效非常好,那么赫赛汀为何会被如此推崇呢,因为赫赛汀可以明显改善患者的生存期,而且与化疗相结合可显着改善HER-2阳性乳腺癌患者的长期生
依维莫司(飞尼妥)显著延长患者无进展生存期6.9个月
2018-03-28作为世界最严重的乳腺癌疾病,目前国内一直停留在化疗和手术阶段,而且每年乳腺癌的发病率在日益上升,而且依维莫司是第一个在ER + HER2-晚期乳腺癌患者中联合激素治疗显示
依维莫司(飞尼妥)将惠及更多肾癌患者
2018-03-28目前肾癌的发病率日益攀升,而且目前已经成为了社会的重大卫生问题,而且肾癌由于早期不容易被发现,所以很多患者都是到了晚期才有所察觉,而且到这种程度其治疗难度已经加大
飞尼妥(依维莫司)印版价格约为多少钱?
2018-03-28说到飞尼妥(依维莫司)我们第一想法就是这事一款最新的乳腺癌药物,除此之外飞尼妥还可以治疗由索拉菲尼治疗失败的晚期肾细胞癌患者,最近尤为贴吧的患者一直咨询飞尼妥印
紫杉醇(安素泰)用法用量?
2018-03-28 据了解,紫杉醇(安素泰)是红豆杉属植物中的一种复杂的次生代谢产物,也是惟一可以促进微管聚合和稳定已聚合微管的药物。
且紫杉醇(安素泰)只结合到聚合的微管上,不
且紫杉醇(安素泰)只结合到聚合的微管上,不
卡巴他赛(Cabazitaxel)哪里有卖的?
2018-03-28前列腺癌在临床中是较为常见的一种男性泌尿生殖系统肿瘤,欧美地区具有极高发病率,在男性恶性肿瘤排名中占第2位。我国前列腺癌发病率虽然少于欧美地区,但也具有逐年增长趋
紫杉醇(安素泰)有副作用吗?
2018-03-28 华印医疗专家表示,是药三分毒,每一种药品在上市后在用于治疗某种疾病的同时必然也会带来一定的副作用。紫杉醇(安素泰)这种药品也不例外。
紫杉醇(安素泰)副作用:
紫杉醇(安素泰)副作用:
紫杉醇(安素泰)的功效如何?
2018-03-28 据了解,紫杉醇(安素泰)适用于卵巢癌和乳腺癌及NSCLC的一线和二线治疗、头颈癌、食管癌,精原细胞瘤,复发非何金氏淋巴瘤治疗等。
紫杉醇(安素泰)功效:
紫杉醇(
紫杉醇(安素泰)功效:
紫杉醇(
紫杉醇注射液的价格是多少?
2018-03-28 据了解,紫杉醇注射液是新型抗微管药物,通过促进微管蛋白聚合抑制解聚,保持微管蛋白稳定,抑制细胞有丝分裂。体外实验证明紫杉醇具有显著的放射增敏作用,可能是使细胞中止
紫杉醇与多西他赛有什么区别?
2018-03-28 近年来,我国癌症发病率和死亡率逐年提高,目前还未有有效的治疗方案。而紫杉醇与多西他赛都是用来治疗癌症的处方药,这两种药品有什么区别呢?我们一起来了解一下。
紫
紫
埃克替尼(凯美纳)服用注意事项有哪些?
2018-03-28 据了解,埃克替尼(凯美纳)主要用于治疗既往接受过至少一个化疗方案失败后的局部晚期或转移性非小细胞肺癌。其中很多患者都选择埃克替尼(凯美纳)来治疗。那么患者在服用埃
正版易瑞沙价格 印度官方给出的是多少钱?
2018-03-28 现在易瑞沙治疗肺癌晚期还是比较普通的选择,由于易瑞沙是靶向药,需要长期服用,但是国内的价格比较贵,尤其是正版易瑞沙价格,但是正版不仅仅是指阿斯利康的易瑞沙,还有正规的印度
色瑞替尼Zykadia说明书上的减量?
2018-03-28目前国内并没有上市色瑞替尼,但是有的患者通过不同的途径购买到药品,主要还是因为色瑞替尼的药效好,患者服用之后有效果,作为靶向药,避免不了出现一些不良情况,针对这些不良
肺癌患者服用色瑞替尼LDK378有生命威胁吗?
2018-03-28色瑞替尼LDK378作为上市不久的一个新药,目前在国内还没有具体的研究,但是在国外的研究已经可以证明,加速审批色瑞替尼LDK378上市是非常正确的,对于患者关心的问题,给大家详
比卡鲁胺失效后可用什么?
2018-03-28众所周知,每一种药物的使用都有一定的时间限制,尤其是抗癌药物比卡鲁胺就是治疗前列腺癌效果不错的药物,但是比卡鲁胺也不能长期使用,因为长期使用同一种药物可能会产生耐
印度阿法替尼与印度塔格瑞斯有什么区别?
2018-03-28 印度阿法替尼与印度塔格瑞斯同为肺癌靶向药,一些患者选择印度阿法替尼来治疗,一些患者选择印度塔格瑞斯来治疗。到底两种药品有什么区别呢?我们一起来看华印医疗专家对此